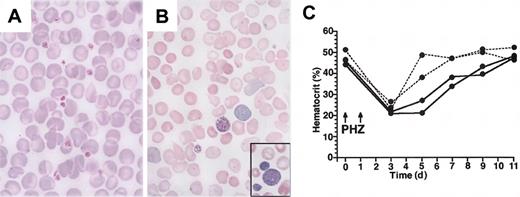
Figure 2. Peripheral blood abnormality in adult V205GR mice. (A) (B) Peripheral blood smears prepared from a V205GR mouse (B; line 1) and a wild-type littermate (A) were stained with Wright-Giemsa and examined by microscopy. Original magnification, × 400. The inset of panel B is at the same magnification, showing giant platelets observed in the same slide outside of the field shown. (C) Hematocrit in the blood of wild-type (dotted line) and V205GR (solid line) mice during recovery from PHZ-induced anemia.

Abstract
Association of GATA-1 and its cofactor Friend of GATA-1 (FOG-1) is essential for erythroid and megakaryocyte development. To assess functions of GATA-1–FOG-1 association during mouse development, we used the GATA-1 hematopoietic regulatory domain to generate transgenic mouse lines expressing a mutant GATA-1, which contains a substitution of glycine 205 for valine (V205G) that abrogates its association with FOG-1. We examined whether the transgenic expression of mutant GATA-1 rescues GATA-1 germ line mutants from embryonic lethality. In high-expressor lines we observed that the GATA-1V205G rescues GATA-1–deficient mice from embryonic lethality at the expected frequency, revealing that excess GATA-1V205G can eliminate the lethal anemia that is due to GATA-1 deficiency. In contrast, transgene expression comparable to the endogenous GATA-1 level resulted in much lower frequency of rescue, indicating that the GATA-1–FOG-1 association is critical for normal embryonic hematopoiesis. Rescued mice in these analyses exhibit thrombocytopenia and display dysregulated proliferation and impaired cytoplasmic maturation of megakaryocytes. Although anemia is not observed under steady-state conditions, stress erythropoiesis is attenuated in the rescued mice. Our findings reveal an indispensable role for the association of GATA-1 and FOG-1 during late-stage megakaryopoiesis and provide a unique model for X-linked thrombocytopenia with inherited GATA-1 mutation.
Introduction
GATA-1 is the founding member of the GATA transcription factor family.1,2 Its expression is abundant in erythroid cells, megakaryocytes, eosinophils, and mast cells within the hematopoietic lineage, and in Sertoli cells of the testis. Gene ablation studies in mice have been performed, and 3 lines of germ line GATA-1 mutant mice have been established that contain a null mutation3 or knock-down mutations either to 5% of the wild-type expression level (designated as GATA-1.05 allele4 ) or 20% of the wild-type expression level (designated as GATA-1low allele5 ). Analyses of these mutant mice have revealed that GATA-1 plays essential roles in the development and differentiation of erythroid and megakaryocytic lineage cells (reviewed in Ohneda and Yamamoto6 ).
In vertebrates, all GATA proteins contain 2 closely spaced zinc finger domains with the characteristic C-X2-C-X17-C-X2-C configuration.1,2 These zinc fingers are highly conserved among the GATA families, and the carboxyl terminal zinc finger (C-finger) is essential for binding to the consensus (T/A)GATA(A/G)–binding sequence in all vertebrate GATA factors. On the other hand, the N-terminal zinc finger (N-finger) is not capable of binding to the sequence by itself, but stabilizes the binding of C-finger to palindromic GATA sites.7,8 In addition, the N-finger recognizes a distinct motif, the core GATC sequence.9,10
Despite the ability of the N-finger to modulate DNA binding, its deletion (ΔNF) does not substantially affect the transactivation activity of GATA-1 in reporter cotransfection analyses that use nonhematopoietic cell lines.11,12 Nonetheless, several lines of evidence suggest that the N-finger of GATA-1 is essential to sustain normal hematopoiesis. For instance, through a transgenic complementation rescue experiment of GATA-1.05 germ mutant mice exploiting the GATA-1 gene hematopoietic regulatory domain (G1HRD), we recently found that ΔNF GATA-1 lacking the N-finger residues 196 to 233 cannot support erythroid cell differentiation during definitive hematopoiesis.12 Similarly, retroviral expression of ΔNF GATA-1 in a GATA-1–deficient erythroid cell line G1E could not induce erythroid maturation.13 This function of the N-finger has been attributed to the capacity of the finger to interact with the cofactor Friend of GATA-1 (FOG-1), a multiple zinc finger protein.14 In erythroid and megakaryocytic cells, the expression of GATA-1 and FOG-1 strongly overlap throughout embryonic development and adult hematopoiesis.14 Retroviral expression of one N-finger mutation, GATA-1V205G, which abrogates the association of GATA-1 with FOG-1, failed to rescue erythroid cell differentiation of a GATA-1–deficient cell line.15
Recently, several missense mutations in the GATA-1 N-finger that diminish association of GATA-1 with FOG-1 have been identified in patients with X-linked anemia and thrombocytopenia.16-19 Interestingly, thrombocytopenia is a common phenotypic consequence in patients with missense mutations in the N-finger of GATA-1, while clinical severity of the anemia correlates with the extent of reduction in GATA-1–FOG-1 association. More recently, targeted knock-in of a GATA-1V205G mutation to its normal location on the X chromosome was reported, and male mice harboring this mutation die by embryonic day 11.5 (E11.5) owing to severe anemia.20 Thus, the embryonic lethal phenotype observed precludes the use of these mice as an animal model for the disease. Generating mice in which the role of the GATA-1–FOG-1 association during megakaryocyte development in vivo can be evaluated requires a different approach.
We report here that transgenic expression of GATA-1V205G cDNA under the control of GATA-1 genomic locus vector efficiently rescues GATA-1.05 germ line mutant mice from embryonic lethality. The rescued mice exhibit severe thrombocytopenia and impaired megakaryocyte differentiation, but no significant anemia; their condition thus resembles X-linked thrombocytopenia. This study clearly demonstrates that the contribution of FOG-1 to GATA-1 function varies between the erythroid and megakaryocytic lineage cells. In contrast to embryonic erythropoiesis, in which the overexpression of GATA-1V205G rescues the GATA-1 deficiency efficiently, the overexpression of GATA-1V205G could not rescue megakaryopoiesis in adult mice, indicating that the GATA-1–FOG-1 association plays a critical role during late-stage megakaryopoiesis. Thus, these rescued mouse lines phenocopy the X-linked thrombocytopenia observed in patients. These lines of mutant mice are expected to serve as a unique model system for the study of human inherited thrombocytopenia.
Materials and methods
Generation of transgenic mice and breeding with GATA-1.05 mutant mice
A DNA fragment including a missense mutation of GATA-1 (V205G; GTG to GGG) was generated by polymerase chain reaction (PCR) and was substituted for the PstI-EcoRI fragment within the murine GATA-1 cDNA. For microinjection, GATA-1V205G cDNA was subcloned into the NotI site of pIE3.9int plasmid expression vector.21 Transgenic mice were generated by microinjection of DNA fragments into fertilized BDF1 eggs by means of standard procedures.22 Founders were screened by PCR, and positives were verified by a Southern blot analysis. The GATA-1.05 allele was monitored by PCR with the use of primers corresponding to the neomycin resistance gene in the original GATA-1.05 targeting vector.4 The expression level of the transgene was evaluated by reverse-transcriptase PCR (RT-PCR) using S1 and AS1 primers based on the sequences in exons IE and II, respectively, as previously described.12
Chroramphenicol acetyltransferase (CAT) assay
QT6 cells were cotransfected with a CAT reporter plasmid containing a GATA site in the promoter, and the expression plasmids for GATA-1 (wild type or mutants) and FOG-1 with the use of Lipofectin (Life Technologies, Bethesda, MD). As a control for transfection efficiency, a plasmid expressing luciferase was cotransfected along with the reporter and expression plasmids and used for normalization. Cells were harvested 48 hours after transfection, and CAT assays were performed as previously described.8
Peripheral blood cell analysis
Mice were bled from the retro-orbital plexus, and hematopoietic indices were determined by means of a hemocytometer (Nihon Koden, Tokyo, Japan). Data were averaged from the analysis of 4 to 6 adult mice. Peripheral blood smears prepared from undiluted blood were stained with Wright-Giemsa stains. In stress erythropoiesis experiments, phenylhydrazine (PHZ) (60 mg/kg body weight) (Sigma, St Louis, MO) was injected intraperitoneally into adult male mice for 2 consecutive days. Peripheral blood samples were taken from the tail vein every 3 days to determine hematocrit.
Histologic and ultrastructural analyses
Whole embryos or hematopoietic tissues dissected from adult mice were fixed in 4% paraformaldehyde followed by embedding in Tissue-Tek OCT compound (Sakura Finetechnical, Tokyo, Japan) and quick-freezing. Cryosections were stained with hematoxylin and eosin or 0.5 mg/mL acetylthiocholiniodide as previously described.23 For electron microscopy, mice were fixed by perfusion with 2% glutaraldehyde prior to excision of hematopoietic tissues. The dissected tissues were fixed in 2% glutaraldehyde overnight at 4°C and processed for routine electron microscopy.
Flow cytometry analysis
Mononucleated cells prepared from bone marrow were stained with fluorescein isothiocyanate (FITC)–conjugated anti-CD41 (BD PharMingen, San Jose, CA) (1:200) for 30 minutes on ice. After washing with phosphate-buffered saline (PBS), viable cells were selected by propidium iodide (PI) staining. FITC-conjugated rat immunoglobulin G2b (IgG2b) was used as an isotype-matched control. The samples were subjected to flow cytometric analysis using FACS Calibur (Becton Dickinson, San Jose, CA).
Assay for colony-forming cells
Bone marrow mononucleated cells were incubated in duplicate at a cell concentration of 1.5 × 105/mL in 1% methylcellulose culture medium containing 15% fetal bovine serum (FBS), 1% bovine serum albumin (BSA), 10-4 M 2-mercaptoethanol, 3 U/mL erythropoietin, 10 ng/mL interleukin 3 (IL-3), 10 ng/mL IL-6, and 50 ng/mL stem cell factor. These cytokines were generous gifts from Kirin Brewery (Tokyo, Japan). The cells were incubated at 37°C in a humidified atmosphere flushed with 5% CO2 in air. Colonies were scored at day 3 for erythroid colony-forming units (CFU-Es) and at day 8 for erythroid burst-forming units (BFU-Es), and granulocyte/macrophage colony-forming units (CFU-GMs). For the megakaryocyte colony-forming units (CFU-Meg's) assay, 1.5 × 105/mL cells were cultured with Mega Cult-C Kit (Stem Cell Technologies, Vancouver, BC, Canada) in the presence of 50 ng/mL thrombopoietin, 10 ng/mL IL-6, and 10 ng/mL IL-3. After 8 days of incubation at 37°C in a humidified atmosphere flushed with 5% CO2 in air, the colonies were stained for acetylcholine esterase (AChE) as described.23
Semiquantitative RT-PCR
Megakaryocytes were purified on a magnetic activated cell sorting (MACS) separation column (Miltenyi Biotech, Auburn, CA) with the use of FITC-conjugated anti-CD41 antibody and anti-FITC microbeads. A small aliquot of the cells was stained for AChE to evaluate purity of megakaryocytes. AChE+ cells were more than 18% of the purified cell fractions used for the RT-PCR analyses. Total RNA was prepared by means of the RNA-sol extraction system (Tel-Test; Iso-Tex Diagnostics, Friendswood, TX). The cDNA was synthesized with reverse transcriptase, and the PCR amplifications were performed with the following primer pairs: platelet factor 4 (PF4), forward, 5′-CTCTTGACATGAGCGTCGCTGCGG-3′, and reverse, 5′-CTTGATCACCTCCAGGCAGGTGAA-3′; platelet basic protein (PBP), forward, 5′-GCCTGCCCACTTCATAACCTC-3′, and reverse, 5′-GGGTCCAGGCACGTTTTTTG-3′; β1-tubulin, forward, 5′-ATCAGGGAGGAGTACCCGGATCGGA-3′, and reverse, 5′-CCCGGAATATACAAGCCACAGTCAG-3′; thromboxane synthase (TXS), forward, 5′-CCTCTGTGTGGGTACTATCTTGG-3′, and reverse, 5′-TGGGACCATTATGGATGGAAATG-3′; c-mpl, forward, 5′-AGCTGCTGTCCACAGAAACC-3′, and reverse, 5′-GTCATTTCGTGACTTGAAGTGGC-3′; glycoprotein IX (GPIX), forward, 5′-AGGCCCTGTACCTGCCAGTCC-3′, and reverse, 5′-GCCCAGCTCATAACCTGTCAGCT-3′; FOG-1, forward, 5′-CTCCCTGTGCAG GAACCAGT-3′, and reverse, 5′-GGGTTTCTCTTCCGTCGCCG-3′. Primer sequences used for NF-E2 p45, MafK, GATA-2, and hypoxanthine phosphoribosyltransferase (HPRT) cDNA amplification were as previously described.24,25
Results
Expression of the GATA-1 HRD–GATA-1V205G transgene rescues GATA-1 germ line mutant mice
We generated 5 lines of transgenic mice that express GATA-1V205G under the control of GATA-1 genomic locus spanning 3.9 kb 5′ of the hematopoietic IE exon to the second exon (GATA-1 HRD) (Figure 1A). GATA-1 HRD recapitulates endogenous GATA-1 gene expression during mouse development very well, if not perfectly.21,26,27 A prior report has shown that the valine 205 to glycine (V205G) substitution markedly reduces FOG association in a yeast 2-hybrid study as well as in a coimmunoprecipitation assay.15
Generation of GATA-1 HRD–GATA-1V205G transgenic mouse lines and transgenic rescue of GATA-1.05 mutant. (A) Murine GATA-1 genomic locus and GATA-1 HRD–GATA-1V205G transgene are schematically illustrated. Exons and 3 core regions of GATA-1 HRD (GATA-1 hematopoietic enhancer [G1HE], double GATA, and CACCC27 ) are indicated. NF and CF correspond to N-terminal and C-terminal zinc fingers, respectively. (B) Transactivation activity of wild-type GATA-1 and GATA-1 mutants in the absence or presence of FOG-1. The increase in CAT activity in response to wild-type GATA-1 was arbitrarily set as 100, and all other samples were expressed relative to this value. The average of 3 independent experiments is shown, and the error bars represent the standard error of the mean (SEM). (C) Transgene-derived GATA-1 and mutant mRNA levels. The mRNA levels were determined by semiquantitative RT-PCR. Reverse-transcribed cDNAs were rendered for 27, 30, and 33 cycles of amplification. Filled arrowheads indicate the migration position expected for transgene-derived GATA-1 amplicon, while open arrowheads indicate the position of endogenous GATA-1 amplicon. (D) Transgenic rescue of GATA-1.05 mutant mice from embryonic lethality. The total number of pups in each transgenic rescue line is indicated. The frequency of V205GR mice is expressed as ratios of the number of V205GR mice observed to that predicted from Mendelian expectations. (E) Transgenic rescue of GATA-1.05 mutant embryos from embryonic lethality. Embryos were genotyped at E14.5. Total number of embryos in each transgenic rescue line is indicated. Frequency of V205GR embryos is expressed as ratios of the number V205GR embryos observed to that predicted from Mendelian expectations.
Generation of GATA-1 HRD–GATA-1V205G transgenic mouse lines and transgenic rescue of GATA-1.05 mutant. (A) Murine GATA-1 genomic locus and GATA-1 HRD–GATA-1V205G transgene are schematically illustrated. Exons and 3 core regions of GATA-1 HRD (GATA-1 hematopoietic enhancer [G1HE], double GATA, and CACCC27 ) are indicated. NF and CF correspond to N-terminal and C-terminal zinc fingers, respectively. (B) Transactivation activity of wild-type GATA-1 and GATA-1 mutants in the absence or presence of FOG-1. The increase in CAT activity in response to wild-type GATA-1 was arbitrarily set as 100, and all other samples were expressed relative to this value. The average of 3 independent experiments is shown, and the error bars represent the standard error of the mean (SEM). (C) Transgene-derived GATA-1 and mutant mRNA levels. The mRNA levels were determined by semiquantitative RT-PCR. Reverse-transcribed cDNAs were rendered for 27, 30, and 33 cycles of amplification. Filled arrowheads indicate the migration position expected for transgene-derived GATA-1 amplicon, while open arrowheads indicate the position of endogenous GATA-1 amplicon. (D) Transgenic rescue of GATA-1.05 mutant mice from embryonic lethality. The total number of pups in each transgenic rescue line is indicated. The frequency of V205GR mice is expressed as ratios of the number of V205GR mice observed to that predicted from Mendelian expectations. (E) Transgenic rescue of GATA-1.05 mutant embryos from embryonic lethality. Embryos were genotyped at E14.5. Total number of embryos in each transgenic rescue line is indicated. Frequency of V205GR embryos is expressed as ratios of the number V205GR embryos observed to that predicted from Mendelian expectations.
We performed a CAT reporter gene transfection assay to confirm the impaired association of this mutant with FOG-1 in a nonhematopoietic cell line, QT6. While FOG-1 efficiently repressed the activity of GATA-1 on a GATA-dependent promoter,28 the transactivation activity of GATA-1V205G as well as GATA-1 ΔNF for the same promoter was comparable in the presence or absence of FOG-1 (Figure 1B). To estimate the transgene expression level, we performed RT-PCR using primers that discriminate endogenous and transgene-derived GATA-1 mRNA.12 Since a 110-bp sequence was added to the 5′-untranslated region of the transgene, the transgene-derived PCR product (360 bp) is longer than that derived from the endogenous gene (250 bp). On the basis of this analysis, we categorized the transgenic lines into 3 groups (Figure 1C). Compared with endogenous GATA-1, the transgene was expressed at significantly higher levels in 2 lines (lines 1 and 2), was comparable in 1 line (line 3), and was lower in 2 other lines (lines 4 and 5). We confirmed that the transgene-derived GATA-1V205G mRNA is translated into protein and binds to a consensus GATA site by Western blotting and electrophoretic mobility shift assay (EMSA), respectively, with the use of nuclear extracts prepared from the spleens of adult transgenic mice (data not shown).
To assess whether association with FOG is required for GATA-1 function in vivo, we then crossed male mice from these transgenic lines with GATA-1.05 knock-down heterozygous female mice. Since the GATA-1 gene is located on the X chromosome, hemizygous GATA-1.05/Y mice do not survive beyond E12.5 owing to defective primitive erythropoiesis.4 We previously reported that transgenic expression of GATA-1 under the control of the GATA-1 HRD efficiently rescued GATA-1.05/Y males from embryonic lethality.29
To our surprise, despite the disturbance of FOG-1 association, the expression of GATA-1V205G rescued GATA-1.05/Y males in all transgenic lines (Figure 1D). We refer to these rescued compound mutant mice (GATA-1.05/Y::G1HRD–GATA-1V205G transgene) as V205GR mice. The frequency of the pups rescued correlated with the expression level of transgene, and only 25% of expected V205GR mice were rescued when the transgene expression was comparable to endogenous GATA-1 expression (line 3, Figure 1D). These results unequivocally demonstrate that the GATA-1–FOG-1 interaction plays a critical role during embryonic hematopoiesis, consistent with the previous report showing that the GATA-1V205G knock-in mutant mice die in utero owing to severe anemia.20 In our preliminary analysis, we found that 2 GATA-1 null/Y mice were rescued by the expression of G1HRD–GATA-1V205G transgene (data not shown). We used the GATA-1 HRD–GATA-1V205G transgenic line, which efficiently rescues GATA-1.05/Y mice (line 1). This result indicates that the residual expression of GATA-1 from GATA-1.05 allele does not contribute to the rescue, but GATA-1 HRD–GATA-1V205G transgene by itself supports the embryonic hematopoiesis.
We also examined the genotype of the embryos at E14.5 and found that frequency of the V205GR mice was comparable among all transgenic lines except line 4 (Figure 1E), indicating that the V205G transgene efficiently rescues GATA-1 deficiency in this stage of embryos even in the medium and low expressors.
V205GR mice exhibit thrombocytopenia and attenuated stress erythropoiesis
The V205GR mice derived from the 2 high-expressor lines (lines 1 and 2) grew normally and were fertile. Importantly, however, these mice exhibit severe thrombocytopenia, but without marked anemia in the adult stage (Table 1). Compared with wild-type mice (Figure 2A), peripheral blood smears of the rescued mice demonstrated anisocytosis and a clear paucity of platelets (Figure 2B). Gross morphologic abnormalities of platelets are also observed (Figure 2B).
Hematopoietic indices of V205GR mice
Mice analyzed . | No. . | Red blood cell count, × 104/μL . | Hematocrit, % . | Hemoglobin, g/dL . | Platelet count, × 104/μL . | White blood cell count, × 102/μL . |
|---|---|---|---|---|---|---|
| Control | 5 | 967 ± 15 | 48.5 ± 0.9 | 13.6 ± 0.2 | 70.1 ± 6.7 | 41 ± 6 |
| V205GR | 5 | 1058 ± 94 | 49.7 ± 3.0 | 13.3 ± 1.2 | 29.4 ± 18.9* | 63 ± 21 |
Mice analyzed . | No. . | Red blood cell count, × 104/μL . | Hematocrit, % . | Hemoglobin, g/dL . | Platelet count, × 104/μL . | White blood cell count, × 102/μL . |
|---|---|---|---|---|---|---|
| Control | 5 | 967 ± 15 | 48.5 ± 0.9 | 13.6 ± 0.2 | 70.1 ± 6.7 | 41 ± 6 |
| V205GR | 5 | 1058 ± 94 | 49.7 ± 3.0 | 13.3 ± 1.2 | 29.4 ± 18.9* | 63 ± 21 |
Mice of 9 to 13 weeks of age were used. Values expressed as means ± SD. Age-matched BDF1 mice were used as controls.
P < .005
Peripheral blood abnormality in adult V205GR mice. (A) (B) Peripheral blood smears prepared from a V205GR mouse (B; line 1) and a wild-type littermate (A) were stained with Wright-Giemsa and examined by microscopy. Original magnification, × 400. The inset of panel B is at the same magnification, showing giant platelets observed in the same slide outside of the field shown. (C) Hematocrit in the blood of wild-type (dotted line) and V205GR (solid line) mice during recovery from PHZ-induced anemia.
Peripheral blood abnormality in adult V205GR mice. (A) (B) Peripheral blood smears prepared from a V205GR mouse (B; line 1) and a wild-type littermate (A) were stained with Wright-Giemsa and examined by microscopy. Original magnification, × 400. The inset of panel B is at the same magnification, showing giant platelets observed in the same slide outside of the field shown. (C) Hematocrit in the blood of wild-type (dotted line) and V205GR (solid line) mice during recovery from PHZ-induced anemia.
Although these mice do not exhibit anemia under steady-state conditions, morphologic abnormalities in peripheral erythrocytes suggest latent dyserythropoiesis in the rescued mice. We therefore tested the response of these mice to PHZ-induced anemia (Figure 2C). Whereas wild-type mice recovered from anemia by day 7, the V205GR mice required 11 days for the complete recovery from the anemia. The attenuated stress erythropoiesis in the V205GR mice is presumably due to a limited expansion of erythroid progenitors in these mice. We conclude here that an association of FOG-1 and GATA-1 is required for the immediate recovery from the acute anemia. The overall phenotype of the rescued mice resembles that of patients with X-linked thrombocytopenia, since these mice show thrombocytopenia without anemia and since their peripheral blood morphology shares features similar to that of the X-linked thrombocytopenia patients.17,18
High expression of GATA-1V205G transgene supports embryonic erythropoiesis
We are interested in the similarity of the phenotypes of V205GR mice and X-linked thrombocytopenia patients, and intend to study the development of erythroid and megakaryocytic lineages in the V205GR mice during embryonic and postnatal stages. The appearance of the V205GR mouse embryos was indistinguishable from that of the wild-type embryos at E9.5 (data not shown), whereas GATA-1.05/Y embryos were invariably pale and small, as previously reported.4 The erythroid cells were positive for GATA-1 immunostaining in the yolk sac of the V205GR mice (data not shown).
At E15.5, mutant phenotypes of rescued embryos were not always obvious (Figure 3A-B), but they could sometimes be identified by their small size and pale appearance compared with wild-type embryos (data not shown). In the V205GR embryos, the circulation of nucleated erythroid cells is often observed, whereas in wild-type circulation the erythrocyte is uniformly enucleated (Figure 3H and 3G, respectively). Although erythroid progenitors are observed in the liver of V205GR and wild-type embryos (Figure 3E and 3D, respectively), enucleated erythroid cells were rarely observed in the V205GR embryo liver (Figure 3E).
Erythropoiesis in E15.5 V205GR and ΔNFR embryos. Macroscopic appearance (panels A-C) of wild-type (panels A, D, G), V205GR (panels B, E, H), and ΔNFR (panels C, F, I) embryos are shown along with hematoxylin and eosin staining of embryonic liver (panels D-F), and circulating erythrocytes observed in large blood vessels (panels G-H). Scale bars correspond to 20 μm.
Erythropoiesis in E15.5 V205GR and ΔNFR embryos. Macroscopic appearance (panels A-C) of wild-type (panels A, D, G), V205GR (panels B, E, H), and ΔNFR (panels C, F, I) embryos are shown along with hematoxylin and eosin staining of embryonic liver (panels D-F), and circulating erythrocytes observed in large blood vessels (panels G-H). Scale bars correspond to 20 μm.
We previously reported that primitive erythropoiesis of the GATA-1.05/Y embryos can be rescued by the transgenic expression of GATA-1 ΔNF mutant (ΔNFR).12 It is of note, however, that erythropoiesis in the ΔNFR mice was much more severely affected than in the V205GR animals. The ΔNFR embryos were uniformly smaller and paler compared with wild-type embryos (Figure 3C), and the majority of the circulating erythrocytes were nucleated (Figure 3I). Moreover, the livers of ΔNFR embryos were small and hypocellular (Figure 3F), whereas no significant difference in size of the fetal liver was observed between the wild-type and V205GR embryos (data not shown). Taken together, these results suggest that the ability to associate with FOG-1 is only one of the required biologic functions of the GATA-1 N-finger, and the other functions are preserved in the V205G mutant (see “Discussion”).
Interaction of GATA-1 and FOG-1 is crucial for megakaryopoiesis
In contrast to erythropoiesis, megakaryopoiesis is severely affected in the V205GR mice. Hematoxylin and eosin staining of the E17.5 liver revealed that the number of megakaryocytes is significantly increased in the rescued mice (arrowheads, Figure 4B) compared with that of wild-type embryos (Figure 4A). Megakaryocytes in the V205GR embryos are larger than those of the wild-type embryos (Figure 4A-B).
Morphologic abnormalities of V205GR megakaryocytes. (A) (B) Histologic examination of E17.5 liver with hematoxylin and eosin staining. Megakaryocytes in the liver of V205GR embryo (B, arrowheads) are increased in number and larger in size compared with those of wild-type littermate (A arrowhead). Scale bar corresponds to 40 μm. (C)–(H) Histologic examination of wild-type (C, D), V205GR (panels E, F), and G1R (G, H) mouse spleens. Spleen sections with hematoxylin-eosin staining (C, E, G) or AChE staining (D, F, H) are shown. Scale bars correspond to 40 μm (C, E, G) and 300 μm (D, F, H), respectively. (I,J) Electron microscopic analysis of megakaryocytes. Megakaryocytes were prepared from bone marrow of wild-type (I; original magnification, ×3000) and V205GR (J; original magnification, ×2000) mice.
Morphologic abnormalities of V205GR megakaryocytes. (A) (B) Histologic examination of E17.5 liver with hematoxylin and eosin staining. Megakaryocytes in the liver of V205GR embryo (B, arrowheads) are increased in number and larger in size compared with those of wild-type littermate (A arrowhead). Scale bar corresponds to 40 μm. (C)–(H) Histologic examination of wild-type (C, D), V205GR (panels E, F), and G1R (G, H) mouse spleens. Spleen sections with hematoxylin-eosin staining (C, E, G) or AChE staining (D, F, H) are shown. Scale bars correspond to 40 μm (C, E, G) and 300 μm (D, F, H), respectively. (I,J) Electron microscopic analysis of megakaryocytes. Megakaryocytes were prepared from bone marrow of wild-type (I; original magnification, ×3000) and V205GR (J; original magnification, ×2000) mice.
An increase of megakaryocytes was also observed in the hematopoietic tissues of adult V205GR mice compared with the wild-type mouse tissues. Again, megakaryocytes in the V205GR mouse spleen (Figure 4E) are significantly larger than those in the wild-type mouse spleen (Figure 4C). These megakaryocytes are positive for AChE (Figure 4D,F); with staining, the significant increase in the number of megakaryocytes in the red pulp of the V205GR mouse spleen (Figure 4F) becomes obvious.
Next, we examined the hematopoietic tissues of G1R mice, the GATA-1.05/Y mice rescued by transgenic expression of wild-type GATA-1.29 In contrast to the V205GR mice, the number and size of megakaryocytes in the spleen of G1R mice was comparable to what was observed in wild-type animals (Figure 4H and 4D, respectively). Since the difference between G1R and V205GR is attributable to the ability to interact with FOG-1, these observations suggest that proliferation of megakaryocytes in V205GR mice is most likely caused by the reduction of GATA-1 association with FOG-1.
Electron microscopic analysis (Figure 4I-J) demonstrates that megakaryocytes of the V205GR mouse contain a large volume of cytoplasm with a paucity of cytoplasmic organelles. The demarcation membrane is extremely underdeveloped in the V205GR megakaryocytes compared with wild-type megakaryocytes (Figure 4J and 4I, respectively). In contrast to the cytoplasmic abnormalities, the degree of nuclear segmentation observed is similar in the V205GR and wild-type megakaryocytes.
Megakaryopoiesis is severely dysregulated in the V205GR mice
To further characterize the apparently defective differentiation of V205GR megakaryocytes, we isolated bone marrow mononuclear cells and examined CD41 expression by flow cytometry (Figure 5A). An increased number of large mononuclear cells was observed in the V205GR mice (upper right panel) compared with wild-type mice (upper left panel), and 95% of the large cells are CD41+ (lower right panel).
Dysregulated megakaryopoiesis in V205GR mice. (A) CD41 expression in bone marrow cells from wild-type (left panels) and V205GR (right panels) mouse. In the total ungated population, 30 000 events were acquired (upper panels). The lower panels show the histogram of CD41+ cells in the gated population of cells shown in the corresponding upper panels. (B,C) Megakaryocyte colonies from wild-type (B) and V205GR (C) bone marrow mononuclear cells. Colony formation assay was performed as described in the text, and megakaryocyte colonies are visualized by AChE staining. Original magnification, × 100.
Dysregulated megakaryopoiesis in V205GR mice. (A) CD41 expression in bone marrow cells from wild-type (left panels) and V205GR (right panels) mouse. In the total ungated population, 30 000 events were acquired (upper panels). The lower panels show the histogram of CD41+ cells in the gated population of cells shown in the corresponding upper panels. (B,C) Megakaryocyte colonies from wild-type (B) and V205GR (C) bone marrow mononuclear cells. Colony formation assay was performed as described in the text, and megakaryocyte colonies are visualized by AChE staining. Original magnification, × 100.
To clarify whether the number of megakaryocyte progenitors increases in the V205GR bone marrow, the mononuclear cells were examined for in vitro colony formation (Table 2). The number of CFU-Megs as well as CFU-Es, BFU-Es, and CFU-GMs is comparable among bone marrow cells from the V205GR mice, male transgenic mice bearing a wild-type allele GATA-1 (X/Y::V205G), and wild-type mice, indicating that hematopoietic progenitor formation is normal in the V205GR mice. However, AChE+ cells of CFU-Megs appeared to be significantly larger in the V205GR cells compared with wild type (Figure 5C and 5B, respectively).
In vitro colony assays using bone marrow cells from V205GR mice
Genotype . | No. mice analyzed . | CFU-E . | BFU-E . | CFU-GM . | CFU-Meg . |
|---|---|---|---|---|---|
| WT | 3 | 26 ± 7 | 10 ± 2 | 149 ± 17 | 22 ± 5 |
| X/Y::V205G | 4 | 26 ± 2 | 10 ± 1 | 140 ± 2 | 20 ± 3 |
| GATA-1.05/Y::V205G | 3 | 22 ± 5 | 6 ± 2 | 159 ± 23 | 27 ± 1 |
Genotype . | No. mice analyzed . | CFU-E . | BFU-E . | CFU-GM . | CFU-Meg . |
|---|---|---|---|---|---|
| WT | 3 | 26 ± 7 | 10 ± 2 | 149 ± 17 | 22 ± 5 |
| X/Y::V205G | 4 | 26 ± 2 | 10 ± 1 | 140 ± 2 | 20 ± 3 |
| GATA-1.05/Y::V205G | 3 | 22 ± 5 | 6 ± 2 | 159 ± 23 | 27 ± 1 |
Colony numbers are expressed per 1.5 × 105 bone marrow mononuclear cells. Values expressed as means ± SD. WT indicates wild type.
We next carried out a proplatelet formation assay, which requires cytoplasmic maturation of the megakaryocytic progenitor cells. Proplatelet formation (PPF) is significantly impaired in the bone marrow cells of V205GR mice when compared with wild-type mice (Table 3). These results, together with the morphologic analyses of megakaryocytes (Figure 4), indicate that the GATA-1–FOG-1 interaction plays an indispensable role in late cytoplasmic development and platelet formation of megakaryocytes in vivo.
Proplatelet formation of V205GR mouse bone marrow cells
. | Magakaryocytes with PPF, % . | . | |
|---|---|---|---|
| Genotype . | Experiment no. 1 . | Experiment no. 2 . | |
| WT | 29.6 | 25.0 | |
| 33.1 | 29.6 | ||
| 24.9 | 31.8 | ||
| V205GR | 13.9 | 16.0 | |
. | Magakaryocytes with PPF, % . | . | |
|---|---|---|---|
| Genotype . | Experiment no. 1 . | Experiment no. 2 . | |
| WT | 29.6 | 25.0 | |
| 33.1 | 29.6 | ||
| 24.9 | 31.8 | ||
| V205GR | 13.9 | 16.0 | |
Expression of megakaryocyte-specific genes in V205GR mice
To investigate how the expression of target genes is affected in the V205GR megakaryocytes, we performed semiquantitative RT-PCR analysis using the enriched CD41+ cell fraction recovered from adult bone marrow cells. Interestingly, in spite of the severe thrombocytopenia and the impaired megakaryocyte differentiation, reduction of the mRNA expression was not observed for all megakaryocyte-specific genes examined (Figure 6). The expression of mRNAs for PF4, PBP, and β1-tubulin was significantly diminished in the rescued mice compared with wild-type mice, whereas the expression of mRNAs for TXS and c-mpl was unaffected. The expression of GPIX mRNA was substantially increased in the rescued mice compared with wild-type mice. We speculate that the complexity of target gene expression profile in the rescued mice may result from FOG-independent GATA-1 function(s) and indirect effects from other transcription factors and cofactors. Indeed, the expression of NF-E2 p45 and a small Maf factor, MafK, both of which are critical for terminal megakaryocyte differentiation,25,30 was significantly decreased in the V205GR bone marrow cells. The expression of GATA-2 was significantly increased in the V205GR megakaryocytes compared with wild-type mouse megakaryocytes. These results suggest that the expression of mRNAs for several megakaryocyte-specific genes is decreased through attenuated expression of megakaryocytic transcription factors and cofactors, such as NF-E2 p45 and MafK.
Expression of megakaryocyte-related genes in V205GR megakaryocytes. Megakaryocytes were isolated from the bone marrow of V205GR and wild-type mice, and the expression of megakaryocyte-related genes and transcription factors was analyzed by semiquantitative RT-PCR. The cDNAproducts were amplified with increasing number of cycles; 31, 34, and 37 cycles for PF4, β1-tubulin, and GATA-2; 34, 37, and 40 cycles for PBP, TXS, c-mpl, GPIX, p45, MafK, FOG-1, and HPRT.
Expression of megakaryocyte-related genes in V205GR megakaryocytes. Megakaryocytes were isolated from the bone marrow of V205GR and wild-type mice, and the expression of megakaryocyte-related genes and transcription factors was analyzed by semiquantitative RT-PCR. The cDNAproducts were amplified with increasing number of cycles; 31, 34, and 37 cycles for PF4, β1-tubulin, and GATA-2; 34, 37, and 40 cycles for PBP, TXS, c-mpl, GPIX, p45, MafK, FOG-1, and HPRT.
Discussion
To elucidate the function of the GATA-1–FOG-1 complex in vivo, we generated 5 lines of transgenic mice expressing GATA-1V205G, which has impaired ability to associate with FOG-1. The transgenic lines placed the mutant GATA-1 cDNA under the transcriptional control of the GATA-1 hematopoietic regulatory domain. We then asked whether transgenic expression of the GATA-1V205G mutant was able to rescue the GATA-1.05/Y knock-down mouse from embryonic lethality. Whereas in high-expressor lines GATA-1V205G rescues GATA-1–deficient mice from embryonic lethality at the expected frequency, transgenic expression of GATA-1V205G at levels comparable to the endogenous GATA-1 level resulted in much lower frequency of rescue, indicating that the GATA-1–FOG-1 association is critical for normal embryonic hematopoiesis. Importantly, mice rescued in these analyses exhibited thrombocytopenia, but not anemia, and displayed dysregulated proliferation and impaired cytoplasmic maturation of megakaryocytes in adulthood. These results thus demonstrate an indispensable role of the GATA-1–FOG-1 complex in erythropoiesis and megakaryopoiesis, and further suggest that the functional contribution of this complex is different in the erythroid and megakaryocytic lineages.
How can the expression of GATA-1V205G transgene rescue erythropoiesis of GATA-1–deficient mice? One plausible explanation is that the GATA-1V205G mutant N-finger still retains an activity that regulates the embryonic erythropoiesis, even in the absence of FOG-1–binding activity. Importantly, in contrast to the situation for V205GR mice, the maturation of definitive erythroid cells is virtually arrested in the ΔNFR embryos that lack the entire N-finger. The difference between ΔNFR and V205GR implies that the N-finger performs multiple functions to support erythroid cell differentiation. A recent study revealed that the N-finger mutation Q216R (a substitution of glutamine for arginine at residue 216) in a human case retains FOG-1 association activity and results in thrombocytopenia with thalassemia, indicating the presence of a FOG-1–independent function of the GATA-1 N-finger in vivo.31
An alternative explanation is that the N-terminal (NT) domain of GATA-1 may compensate for the lack of FOG-1 association. We previously found that the NT domain and N-finger of GATA-1 complement each other during primitive erythropoiesis.12 Transgenic rescue experiments revealed that, while the expression of a GATA-1 mutant that lacks both NT and N-finger cannot support primitive erythropoiesis, a GATA-1 mutant lacking either the NT domain or the N-finger retains compensatory activities during primitive erythropoiesis.12 In the case of the V205GR mice, abundant expression of the V205G transgene may supply a sufficient amount of the NT domain to compensate for the lack of FOG-1 association. Another possibility is that the association of GATA-1V205G mutant with FOG-1 is reduced but not entirely disrupted, so that minimal FOG-1 association is achieved in erythroid cells of the high expressors. Although we cannot fully exclude this possibility with current data, CAT assay data as well as in vitro15 and ex vivo32 binding assays argue against this hypothesis.
It has been shown that FOG-1 function during early megakaryopoiesis is independent of GATA-1. FOG-1–deficient mice fail to produce megakaryocytes, and FOG-1–deficient embryonic stem (ES) cells generate no megakaryocytic colonies in vitro.33 By contrast, megakaryocytes can be produced in mice specifically lacking GATA-1 in the megakaryocytic lineage,5,34 indicating that GATA-1 is not required for the initial stage of megakaryopoiesis. However, megakaryocytes in these mice exhibit aberrant proliferation and maturation arrest.5,34 We compared the phenotype of V205GR mice with that reported for the mouse lacking GATA-1 in megakaryocytes and found that development of megakaryocytes is more broadly and profoundly impaired in the lineage-specific GATA-1 deficiency, especially at the earlier developmental stages. For instance, GATA-1–deficient megakaryocytes are smaller than wild-type megakaryocytes, with smaller volume of cytoplasm and condensed nuclei.5 Electron microscopic analysis revealed that GATA-1–deficient megakaryocytes show maturation arrest in both nuclear and cytoplasmic compartments,34 whereas the maturation arrest is more prominent in the cytoplasm than in the nucleus of V205GR megakaryocytes. Phenotypic features of V205GR megakaryocytes are similar to those of NF-E2 p45-deficient mice.30 Large megakaryocytes, one of the characteristic features of V205GR mice, have also been observed in the p45-deficient mice. Whereas the expression of β1-tubulin mRNA was reduced in V205GR mice, it was virtually absent in the p45-null mice. Reduced expression of p45 and MafK was also noticed in V205GR mice. We surmise that this may explain the phenotypic similarity between the p45-/- and V205GR megakaryocytes, in that FOG-1–dependent function of GATA-1 during the late stage of megakaryocyte development may be mediated, at least in part, through the activation of NF-E2 p45 and MafK gene expression.
Previous studies showed that GATA-1 and FOG-1 synergistically activate transcription of p45 gene in a transfection study.14 An in vitro differentiation study of GATA-1V205G, ES cells revealed a decrease in p45 mRNA level compared with wild-type ES cells.35 These observations are consistent with the RT-PCR results in this study using V205GR megakaryocytes. However, expression profiles of megakaryocytic genes in V205GR mice are not completely consistent with previous results. For example, whereas synergistic activation of c-mpl gene promoter by GATA-1 and FOG-1 was shown in a transfection assay and c-mpl mRNA was reduced in megakaryocyte-enriched embryoid bodies derived from GATA-1V205G ES cells,35 the expression of c-mpl is largely unaffected in the V205GR megakaryocytes. This discrepancy might be due to the complex gene regulation in vivo and/or to the different developmental stages examined in the studies.
In V205GR megakaryocytes, overexpression of GATA-1V205G might activate the expression of several megakaryocyte-specific genes. In this regard, cooperation of GATA-1 and Friend leukemia integration–1 (Fli-1), an Ets family transcription factor, may play a critical role in the compensatory function of GATA-1V205G. Several megakaryocytic genes, including c-mpl, αIIb, GPIbα, and GPIX, contain tandem GATA and Ets elements in their regulatory sequence.35,36 The Ets elements near GATA sites of these promoters have been shown to play critical roles in the synergistic transcriptional activation by GATA-1 and FOG-1, and Fli-1 has been shown to mediate synergistic activation of GATA-1 and FOG-1.35 Even in the absence of FOG-1, however, both Fli-1 and GATA-1 physically interact with each other and synergistically activate GPIbα and GPIX promoters through cooperative DNA binding.36 In V205GR megakaryocytes, it is thus likely that association of Fli-1 and GATA-1V205G rescues the expression of GATA-1–FOG-1 target genes.
It is interesting to note that in human cases the disruption of GATA-1–FOG-1 interaction also resulted in severe thrombocytopenia without anemia.17,18 Among the GATA-1 mutants found in the patients, GATA-1 with a single amino acid substitution of glycine 208 to serine (G208S) and aspartic acid 218 to glycine (D218G) retain their ability to interact with at least 1 of the 4 FOG-1 zinc fingers that are required for physical interaction with GATA-1.17,18 We envisage that this remnant interaction might be sufficient to support erythropoiesis, whereas even partial disruption of the GATA-1–FOG-1 physical interaction may affect megakaryopoiesis. These observations in human cases seem not to correspond simply with the retroviral rescue experiment of a FOG-1–deficient cell line, in that restoration of the activity of a FOG-1 mutant retaining one intact GATA-1–interacting zinc finger was sufficient to rescue both erythroid and megakaryocytic differentiation of the cells in vitro.37 The discrepancy might be due to the complexity of in vivo megakaryopoiesis controlled by the GATA-1–FOG-1 association versus that observed in a cell line. Studies of erythroid and megakaryocytic gene promoters also revealed clear differences between the GATA-1–FOG-1 machinery in these 2 lineages. Synergistic gene activation by GATA-1 and FOG-1 has been reported in some megakaryocyte-specific promoters, such as αIIb and c-mpl35 but has not been reported for erythroid promoters, and FOG-1–mediated repression of GATA-1 activity has been reported in erythroid-specific EKLF and M1α genes.28 We found in this study that excess GATA-1V205G mutant protein abrogates lethal anemia that is owing to GATA-1 deficiency, but it cannot rescue megakaryocyte differentiation and platelet formation, demonstrating that the GATA-1–FOG-1 association is indispensable for megakaryopoiesis. These findings further support the contention that the GATA-1–FOG-1 machinery contributes differentially to erythropoiesis and megakaryopoiesis.
We have been analyzing transcription factor function in vivo in the mouse for some time. We previously demonstrated a unique contribution of 3 separate domains of GATA-1 using a transgenic complementation rescue analysis. Here we established the temporal sequence of the contribution of a single amino acid of GATA-1 to 2 different hematopoietic lineages. We believe that through this type of approach, we can precisely elucidate the elaborate regulation executed by the GATA family and other transcription factors operating in vivo.
Prepublished online as Blood First Edition Paper, December 4, 2003; DOI 10.1182/blood-2003-07-2514.
Supported by grants from Japan Science and Technology Corporation–ERATO Environmental Response Project, the Ministry of Education, Science, Sports and Culture, The Ministry of Health, Labor and Welfare, and the Naito Foundation.
The publication costs of this article were defrayed in part by page charge payment. Therefore, and solely to indicate this fact, this article is hereby marked “advertisement” in accordance with 18 U.S.C. section 1734.
We would like to thank Drs Satoru Takahashi, Masaki Nakazawa, and Osamu Ohneda for discussion, and Kirin Brewery for generous supply of cytokines. We also thank Ms Reiko Kawai, Yuko Kikuchi, and Naomi Kaneko for help.

![Figure 1. Generation of GATA-1 HRD–GATA-1V205G transgenic mouse lines and transgenic rescue of GATA-1.05 mutant. (A) Murine GATA-1 genomic locus and GATA-1 HRD–GATA-1V205G transgene are schematically illustrated. Exons and 3 core regions of GATA-1 HRD (GATA-1 hematopoietic enhancer [G1HE], double GATA, and CACCC27) are indicated. NF and CF correspond to N-terminal and C-terminal zinc fingers, respectively. (B) Transactivation activity of wild-type GATA-1 and GATA-1 mutants in the absence or presence of FOG-1. The increase in CAT activity in response to wild-type GATA-1 was arbitrarily set as 100, and all other samples were expressed relative to this value. The average of 3 independent experiments is shown, and the error bars represent the standard error of the mean (SEM). (C) Transgene-derived GATA-1 and mutant mRNA levels. The mRNA levels were determined by semiquantitative RT-PCR. Reverse-transcribed cDNAs were rendered for 27, 30, and 33 cycles of amplification. Filled arrowheads indicate the migration position expected for transgene-derived GATA-1 amplicon, while open arrowheads indicate the position of endogenous GATA-1 amplicon. (D) Transgenic rescue of GATA-1.05 mutant mice from embryonic lethality. The total number of pups in each transgenic rescue line is indicated. The frequency of V205GR mice is expressed as ratios of the number of V205GR mice observed to that predicted from Mendelian expectations. (E) Transgenic rescue of GATA-1.05 mutant embryos from embryonic lethality. Embryos were genotyped at E14.5. Total number of embryos in each transgenic rescue line is indicated. Frequency of V205GR embryos is expressed as ratios of the number V205GR embryos observed to that predicted from Mendelian expectations.](https://ash.silverchair-cdn.com/ash/content_public/journal/blood/103/7/10.1182_blood-2003-07-2514/6/m_zh80070459380001.jpeg?Expires=1765911585&Signature=XVAVq1uQTYWAb8W70juPu5qIl83s5bbaz8gA950~T1NQaJ9UA5HMWn5Q-u8Wfe~X20geKa3ENZ04XwE-b4WFkEFPdkFjqsOdHIUAeiagmp8bm7IV~X3dFVSy6t6bz4X2N0Pdf5Yywcilu5i96mk34lt1ImFc0xAVvciyRQjySxW4Zw~0g4tCB9-rkMOrbmSXCzRR5bfYeTyI~Fm0Sv-1VCilfa58zjjk6ht57XpJOxfrUOgpZwq-hT~i~gaignXGvekvU7sJTRLewMsuF4pBMdcAZ0QZn1Vcmryfj1B1elxANLxtiUfAGibb8HgkIDyvWNRdbKVSTVYjiLNG~CACsQ__&Key-Pair-Id=APKAIE5G5CRDK6RD3PGA)

This feature is available to Subscribers Only
Sign In or Create an Account Close Modal